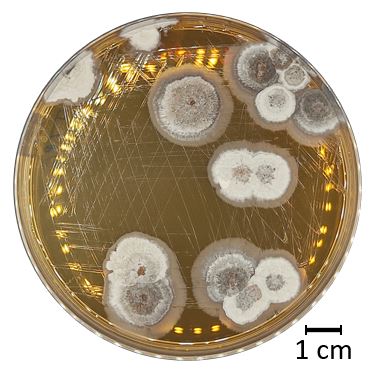
Mathematician John Horton Conway

iGEM: International genetically engineered machine
Summer 2022 ~ @TitouanCh
In 2022, I took part in the iGEM competition for the GO Paris-Saclay team... read some details about my experience here or check out the team wiki.
Introduction
In 2022, I had the opportunity to participate in the IGEM competition and represent my university, engaging in the exciting field of synthetic biology. Engineering the genetic material of organisms creating sorta... artificial life.
My main roles were building the team's wiki and, perhaps more interestingly, modeling the metabolism of our microorganism of interest: strains of Streptmocyces.
More precisely, we wanted to model the impact of introducing a CO₂ fixation module into Streptomyces, possibly changing it from a heterotrophic organism into an autotrophic organism or more realisticly into a hemiautotrophic organism.
S. bottropensis culture inside a petri dish

S. bottropensis culture seen from a microscope
Modeling a metabolic network
I began by filtering through the extensive dataset of metabolic reactions by Streptomyces, specifically focusing on those directly or indirectly associated with CO₂ fixation. This data was sourced from KEGG (Kyoto Encyclopedia of Genes and Genomes).
I decided to model these enzymatic reactions of streptomyces as an array of differential equations. The change in the quantity of metabolite at any point being dependant on the other metabolites. This approach was inspired flux based analysis, a common approach when studying metabolic networks.
Solving the equations
To explore the dynamics of my model, I developed a simple simulator. This tool enabled me to simulate different scenarios by adjusting initial parameters and observing the resulting changes in metabolite quantities over time. Here is a screenshot of the software I developped:

Screenshot of the simple simulator I developped for the competiton
Interestingly, I developed the entire software using the Godot game engine, which, admittedly, isn't the ideal tool for the job. However, due to the time constraints imposed by the competition, this way of working proved to be a remarkably swift way to iterate while keeping our simulator very visual, an essential asset for promoting and communicating our project.
Conclusion
In the end the model was somewhat useful, it seemed to show that our project was at least possible in theory. But of course, we needed to move to bench experiments before anything more could be infered.
For more details, I invite you to check out our team wiki.